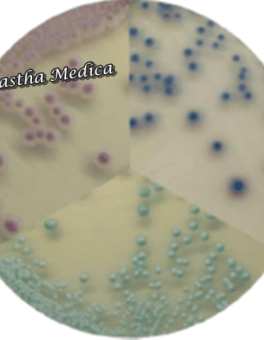
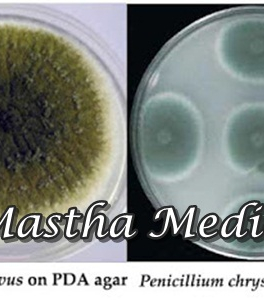

● online
- Jual Tensi Tensimeter Digital Sphygmomanometer Abn....
- Permainan Kasino Berputar Online....
- 247 Blackjack Casino Id 2025 Review....
- Unduhan Mesin Judi Online Kasino Gratis....
- Ios Kasino Bonus Sambutan Tanpa Deposit....
- Bagaimana Menghasilkan Uang Dengan Kasino....
- Timbangan Bayi Gantung Digital Elektrik Electric S....
- Winall Casino 50 Free Spins....
NB : UNTUK PENGIRIMAN WAJIB MENGGUNAKAN EKSPEDISI JNE YES Ik Media Tumbuh Mueller Hinston Agar Disposable Alat laboratorium 1 Pack Mueller Hinston Agar adalah media pertumbuhan mikrobiologis atau bakteri yang terbuat dari bahan plastik yang biasanya digunakan untuk pengujian kerentanan antibiotik. Spesifikasi : – Nama : mueller hinston agar – isi 1 pack :… selengkapnya
Rp 800.000 Rp 1.050.000NB : UNTUK PENGIRIMAN WAJIB MENGGUNAKAN EKSPEDISI JNE YES Ik Media Tumbuh Plate Alat Laboratorium Brain Heart Infusion Agar 1 pack Brain Heart Infusion Agar adalah media serba guna yang cocok untuk budidaya berbagai jenis organisme, termasuk bakteri, ragi dan jamur. Spesifikasi : – Nama : Brain Heart Infusion – Media siap pakai – Sekali… selengkapnya
Rp 800.000 Rp 1.050.000NB : UNTUK PENGIRIMAN WAJIB MENGGUNAKAN EKSPEDISI JNE YES Ik Media Plate Tumbuh Bakteri Alat Lab Chocolate Agar Disposable 1 Pack Chocolate agar adalah media pertumbuhan nonselektif yang digunakan untuk isolasi bakteri patogen. Spesifikasi : – Nama : Chocolate Agar – Media siap pakai – Sekali pakai – Langsung tanam – jumlah 1… selengkapnya
Rp 1.155.000 Rp 1.185.000NB : UNTUK PENGIRIMAN WAJIB MENGGUNAKAN EKSPEDISI JNE YES Ik Alat Laboratorium Candida Chromogenic Media Tumbuh Bakteri Candida Candida chromogenic adalah perkembangbiakan pada bakteri candida. candida ini memiliki [ciri khasnya ada warna hijau ama merah muda yg pudar yang menyebabkan infeksi pada mukosa mulut yg di iringi adanya pertumbuhan jamur. Spesifikasi : – Nama :… selengkapnya
Rp 1.035.000 Rp 1.095.000ik NB : UNTUK PENGIRIMAN WAJIB MENGGUNAKAN EKSPEDISI JNE YES Ik Media Tumbuh Cystine Lactose Electrolytes Deficient CLED Agar 1 Pack Cled agar adalah media yang mendukung pertumbuhan bakteri patogen dan kontaminan dalam urin, tetapi mencegah timbulnya terlalu banyak spesies Proteus yang disesebabkan oleh larutan urin yang kaya akan elektrolit. Spesifikasi : – Nama… selengkapnya
Rp 800.000 Rp 1.045.000Ik Masker Cpr Mouth to Mouth Mask Pocket Resucitator Portable CPR Masker Pocket CPR Mask dirancang untuk bantu pernafasan dari mulut ke mulut. Katup satu arah dan arah diafragma, memungkinkan tidak ada aliran balik dari udara atau kontaminan dari pasien ke penyelamat. Dirancang untuk memenuhi dewasa, anak dan bayi. Kelebihan : Lembut Tahan terhadap… selengkapnya
Rp 175.000 Rp 215.000tl Media Tumbuh Sabouraud Dextrose Agar Plate Alat Laboratorium SDA 1PackSabouraud Dextrose Agar adalah media berbentuk padat (solid) atau media selektif yang digunakan untuk pertumbuhan jamur dan menghambat pertumbuhan bakteri.Spesifikasi :– Nama : Sabouraud Dextrose Agar– Jenis : Media Mikroorganisme– isi : 10 pcs– Jumlah : 1 pack– Sekali pakai– jumlah 1 pack– 1… selengkapnya
Rp 800.000 Rp 1.115.000NB : UNTUK PENGIRIMAN WAJIB MENGGUNAKAN EKSPEDISI JNE YES Ik Media Tumbuh Thiosulfate Citrate Bile Salt Sucrose Plate TCBS 1 Pack Tcbs merupakan media selektif yang digunakan untuk isolasi spesies vibrio dari specimen berak ( stool) yang mengaduk bakteri campuran. Spesifikasi : – Nama : Thiosulfate Citrate Bile Salt Sucrose Plate – jenis :… selengkapnya
Rp 800.000 Rp 1.250.000NB : UNTUK PENGIRIMAN WAJIB MENGGUNAKAN EKSPEDISI JNE YES Ik Media Tumbuh Bakteri PDA Plate Potato Dextrose Agar 1 Pack Potato dextrose agar merupakan salah satu media yang baik digunakan untuk membiakkan suatu mikroorganisme, baik itu berupa cendawan/fungsi, bakteri, maupun sel mahluk hidup. Media PDA merupakan jenis media biakan dan memiliki bentuk/ konsistensi padat… selengkapnya
Rp 800.000 Rp 1.015.000